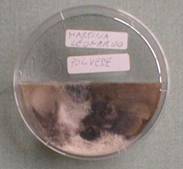

Esplorazione e introduzione del concetto di INTERAZIONE
Scuola Elementare Castelnuovo (Recanati) Ins. Maria Teresa Piattoni, classe 3^
La maestra ha portato a scuola questi materiali ed oggetti:
� Lana di ferro,
� Magnete,
� Guscio d�uovo,
� Infuso di radicchio filtrato,
� Aceto,
� Bicarbonato.
Abbiamo formato quattro gruppi. Ogni gruppo aveva un vassoio di alluminio con dei bicchieri di plastica trasparenti vuoti ed altri di plastica bianca. Abbiamo abbinato i materiali a coppie, usandone solo una parte ogni volta.
Dovevamo scoprire pi� cambiamenti possibili.
In ogni gruppo � stato scelto un responsabile della registrazione dei dati.
Abbiamo avuto a disposizione anche un secchio con acqua pulita e uno vuoto per scaricare i risultati delle prove e sciacquare i contenitori.
La maestra e il tutor hanno costruito alla lavagna una tabella a doppia entrata con i 5 materiali in riga e in colonna nello stesso ordine;hanno poi numerato le caselle coorrispondenti ad ogni diverso abbinamento da 1 a 10.
|
|
G |
A |
R |
F |
B |
|
G |
X |
|
|
|
|
|
A |
1 |
X |
|
|
|
|
R |
2 |
5 |
X |
|
|
|
F |
3 |
6 |
8 |
X |
|
|
B |
4 |
7 |
9 |
10 |
X |
Legenda
G = guscio
A = aceto
R = radicchio
F = lana di ferro
B = bicarbonato
Infine abbiamo registrato le osservazioni e i cambiamenti ottenuti.
1) Guscio + aceto= bollicine soprattutto sulla parte esterna del guscio.
2) Guscio + radicchio = il radicchio non � cambiato,il guscio si � scurito nella parte interna.
3) Ferro + guscio = nessun cambiamento.
4) Bicarbonato + guscio = nessun cambiamento.
5) Aceto + radicchio = si ottiene un colore rosato.
6) Aceto + ferro = nessun cambiamento.
7) Bicarbonato + aceto = molta schiuma e bollicine: il bicarbonato si � sciolto.
8) Ferro + radicchio= il ferro diventa scuro; il radicchio pi� scuro.
9) Bicarbonato + radicchio = colore verde oliva.
10) Ferro + bicarbonato= nessun cambiamento.
Abbiamo osservato che si sono verificati casi in cui c�� stata azione tra l�uno e l�altro materiale.
C�� stata quindi una INTERAZIONE cio� una AZIONE tra due cose, oggetti o materiali.
Abbiamo osservato che ci sono stati casi di NON INTERAZIONE ( non si sono verificati casi di cambiamenti rilevanti).
Dopo aver capito il concetto di INTERAZIONE il prof. Tifi ci ha fatto altri esempi, chiedendo ogni volta se c�era interazione e perch�.
Esempi
-
Le piccole pagliuzze di ferro nel bicarbonato secco si radunavano e si muovevano girando la calamita sotto il foglio di carta dove i due materiali erano mescolati.
-
Il bicarbonato da grigio ritornava bianco e il ferro risultava immutato.
Non c�era stata nessuna interazione tra i due materiali, ma c�era stata interazione tra calamita e ferro.
-
Il temperino aguzza la matita,ma la matita cosa fa al temperino?
Il temperino ha trasformato la matita, la matita non ha cambiato il temperino, MA il temperino dopo tanto uso si consuma quindi si sar� INTERAZIONE.
-
Abbiamo osservato una bussola: la punta rosa dell�ago indicava sempre la direzione NORD anche cambiando posizione. Si capiva che interagiva con qualcosa che doveva trovarsi fuori della bussola.
Ci sono tanti altri esempi di interazione: forbici_carta, gesso_lavagna, termosifone_aria, cibo_corpo, sega_legno, coltello_carne�
NOI ABBIAMO ILLUSTRATO IL DIARIO DI BORDO CON I NOSTRI DISEGNI:
|
|
 |
|
|
|
|
|
|
ED ORA ESERCITIAMOCI A TROVARE ALTRE INTERAZIONI:
-
Cartone pinzatrice: se prendi una pinzatrice e poi pinzi il cartone, vengono i buchi sul cartone e la pinzatrice consuma i ferretti dentro.
-
Di mattina, quando faccio colazione metto prima il cacao dopo butto il latte tiepido e quando ho riempito la tazza vedo il latte di colore marrone, perch� il cacao si � sciolto nel latte .
-
Il cacao � diventato una cosa sola con il latte. Il latte ha il profumo e il sapore di cacao .Una cosa che ho notato � che non posso pi� riprendere il cacao dentro il latte
-
Io prendo la macchina per cucire e del filo, questo lo faccio passare nei vari spazi. Prendo una stoffa la metto sotto l�ago, inizio a muovere il pedale che contemporaneamente muove la stoffa e si forma una cucitura. E� una interazione perch� sulla stoffa rimane il filo mentre sulla spoletta diminuisce.
- l rossetto e le labbra interagiscono perch� il rossetto si consuma, ma protegge lo stesso le labbra. Questa � un� interazione.
Classe 3� _ Castelnuovo